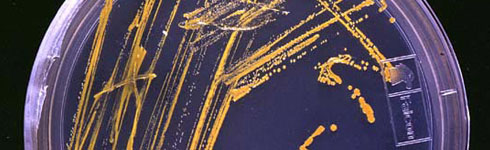

Home » Milestones of Innovation
Milestones of Innovation
Milestones of Innovation
The AIMBE Milestones of Innovation showcases the seminal advancements in both Medical and Biological Engineering over more than the past 100 years. These technologies represent the great achievements of the bio/medical engineering community. The great achievements of the AIMBE College of Fellows are also represented in the more recent technologies but the spirit of innovation and the goal of greater human health and happiness is found in them all.
The time references reflect the decade in which each innovation came into common use. For some, initial development actually had come years earlier – but this chronology denotes their wide acceptance by medical professionals.
Scroll through the AIMBE Milestones of Innovation or select a Milestone to learn more.
1950s and Earlier
Artificial Kidney
Once, kidney failure meant certain death. The advent of dialysis treatment to remove deadly impurities from the blood meant patients’ lives could be saved. For some, dialysis has become a way-station to the long-term solution of a kidney transplant.

X-Ray
Among the first major “high tech” devices used in medicine, X-Rays have been in common use for almost a century as a diagnostic tool. In radiotherapy, X-Rays are used to treat certain diseases, notably cancer, by destroying malignant tumor cells with X radiation.

Electrocardiogram
The EKG is used to measure the rate and regularity of heartbeats as well as the size and function of the heart chambers, the presence of any damage to the heart, and the effects of drugs or devices used to regulate the heart (such as a pacemaker). EKG screenings have been instrumental in helping physicians reduce rates of death and debilitation from heart disease.

Cardiac Pacemaker
Many people who have an abnormal heart rhythm run the risk of sudden death if that heart rhythm gets out of control. A cardiac pacemaker can significantly reduce the risk of sudden death by providing a small, controlled electric current when needed to maintain steady rhythm.

Antibiotic Production Technology
During and after World War II, there was explosive growth in the number of antibiotics being discovered and found useful to treat various conditions. However, it was the development of engineering technologies to mass produce those antibiotics that allowed them to come into general use.

Cardiac Pacemaker
Many people who have an abnormal heart rhythm run the risk of sudden death if that heart rhythm gets out of control. A cardiac pacemaker can significantly reduce the risk of sudden death by providing a small, controlled electric current when needed to maintain steady rhythm.
1960s
Defibrillator
When a patient goes into cardiac arrest, the defibrillator is used to shock the heart back into action. Since the original engineering achievement to design the device, a series of additional engineering enhancements to make it smaller has allowed the defibrillator to move out of the hospital operating room or emergency room and into the hands of emergency response personnel treating patients in offices, shopping centers, airports and even homes and schools.

Heart Valve Replacement
Replacement heart valves were an early example of engineers and clinicians working together to restore cardiac function for patients facing incapacitation because their own valves were failing. Over the years, engineers have developed new designs and materials that allow valves made with synthetic and natural materials to replace damaged or diseased valves.

Intraocular Lens/Contact Lens
The plastic intraocular lens (IOL) has helped restore full vision to those whose sight had grown cloudy due to cataracts (the leading cause of blindness worldwide) or other diseases. Collaboration among biomaterials engineers, mechanical engineers, optical engineers and surgeons has led to a variety of IOLs to fit different patient needs. These artificial lenses are inserted in an outpatient procedure taking only a few hours. While the intraocular lens has restored normal vision to people with cataracts, the contact lens – which preceded it in general use – has proven critical for the functioning of numerous people with caratoconus and other maladies and psychologically important for those who have problems with eyeglasses. Having evolved from an expensive, uncomfortable glass device in the 1930s to an affordable, easy-to-use (and, in many cases, disposable) item today, contact lenses are used by tens of millions of people worldwide.

Ultrasound
For many parents, ultrasound has provided their first “picture” of their unborn child. Through creative engineering, ultrasound also is used to examine many other internal organs, including the heart, carotid arteries, kidneys and bladder. Ultrasound technology uses high-frequency sound waves to get its images – in the same way that submarines use sonar to detect other vessels.

Blood Analysis & Processing
The field of clinical laboratory medicine was revolutionized by the Coulter Principle, which established the reference method for counting and sizing particles. This led to instrumentation that automated the complete blood count or CBC. Today, it is the most commonly utilized diagnostic test worldwide.

1970s
Computer Assisted Tomography (CT)
The integration of computer and X-ray imaging technologies was a landmark engineering feat, allowing radiologists to achieve great breakthroughs in the diagnosis and treatment of certain diseases. CT technology provided an unprecedented cross-sectional picture of the body. In cancer for example, CT is used to detect a tumor, provide information about the extent of the disease, help plan treatment, and determine whether the cancer is responding to treatment.

Artificial Hip & Knee Replacement
Before the advent of artificial hip and knee joints, millions of people – particularly the aged – lived with considerable pain and very limited mobility. Engineers developed designs that can be customized to meet patients’ various needs. Famed golfers Arnold Palmer and Jack Nicklaus are among the millions who still lead active lives thanks to their artificial hips.

Balloon Catheter
The balloon catheter is like a ship in a bottle, symbolizing the engineering finesse and determination required to reach remote body locations through tiny holes. This less invasive technology allows for a fantastic voyage of exploration and treatment for a wide range of conditions, with reduced risk, cost and recovery time.

Endoscopy
Before the endoscope, exploratory surgery often was needed to diagnose and treat patients. The engineering achievement of combining a miniature camera with a flexible tube provided a minimally invasive way to perform a broad range of diagnoses and treatments, with considerably lower risk and cost.

Biological Plant & Food Engineering
In addition to the many medical achievements in the AIMBE Hall of Fame, biological engineering achievements that have increased the quantity and safety of food have benefited people not only in the United States but even more profoundly in life-sustaining ways around the world.

Cochlear Implants and Stimulators
Cochlear implants and stimulators have provided functional hearing to more than 100,000 patients with profound or severe deafness, and millions more potentially could benefit from the technology. The devices allow people of all ages – whether they were born without functional hearing, or lost their hearing later in life – to participate more or less normally in a society in which both social and business interactions often depend on acoustic speech and hearing.

1980s
Artificial Kidney
Once, kidney failure meant certain death. The advent of dialysis treatment to remove deadly impurities from the blood meant patients’ lives could be saved. For some, dialysis has become a way-station to the long-term solution of a kidney transplant.
Laser Surgery
Laser surgery is an interesting example of engineers’ ability to successfully apply an industrial technology for a wide range of medical uses. The pulsed dye laser was the first laser designed for a specific medical application, unsightly birthmarks. Some of the innovative applications include cancer treatment, aesthetic surgery and vision enhancement surgery.

Vascular Stents
Vascular stents are an interesting example of how engineers continuously refine a concept over several product generations. The technology has evolved from a wire mesh tube to hold open an artery to more sophisticated devices – including the drug-eluting stents that have emerged over the past decade.

Recombinant Therapeutics
Engineers developed the enabling technologies to manufacture products of biological origin – or to treat biological activity – that are now a key component of the biopharmaceutical industry. For example, cells that manufacture therapeutic protein molecules form the basis for innovative and important drugs that could not be generated any other way. Recombinant technologies were first introduced in the 1970?s and by the following decade they were applied on an industrial scale, yielding proteins to treat diabetes, heart attacks, and cancer and to moderate the impact of immune deficiencies.

Flow Cytometer and Cell Sorter
The flow cytometer and cell sorter are devices used today in every major university, medical school, hospital, research institute, and pharmaceutical company in the world. The technology has revolutionized the study of the immune system and cancer, and today is driving emerging areas of biomedical research such as proteomics and systems biology. Flow cytometry and cell sorting has emerged as the analytical method of choice for the diagnosis and monitoring of treatment for blood-based diseases ranging from leukemia to HIV/AIDS. In fact, the maturation of flow cytometry technology in the early 1980’s coincided with the emergence of HIV/AIDS as a major public health problem.

Pulse Oximeter
With the introduction of Pulse oximetry, a non-invasive, continuous measure of patient’s oxygenation was possible, revolutionizing the practice of anesthesia and greatly improving patient safety. Prior to its introduction, an estimated 2,000-10,000 Americans died each year from anesthesia-related complications, and many more were made ill.

Digital Hearing Aid
The digital hearing aid – small enough to be positioned virtually out of sight in the inner ear – has improved the quality of life for millions of people. The device allows a wearer not only to talk to friends and family, but also to enjoy music, theater, television and other activities. Primitive electronic hearing aids with vacuum tubes began to appear in the 1920s; transistors revolutionized analog hearing aids in the 1960s and digital hearing aids came about in the 1980s. Advances in microphone design, speech processing, molding techniques, zinc-air batteries and instrumentation for the audiologist all contributed and continue to evolve improved performance.

1990s Until Today
Genomic Sequencing & Micro-arrays
While the Human Genome Project has dominated the headlines in recent years, it would not have been possible without engineering achievements in DNA sequencing and micro-arrays. These tools have allowed researchers to identify the genes within human DNA. In time, this is expected to lead to fundamental breakthroughs in the practice of medicine.

Positron Emission Tomography (PET)
The PET Scan is the latest engineering breakthrough in imaging technology and an important supplement to CT Scanning and MRI. PET technology allows doctors to observe cellular-level metabolic changes with powerful cross-section images of the body. PET Scans are now used to detect some cancers, coronary heart disease and brain disorders.

Image-guided Surgery
Image-guided surgery allows the surgeon to use imaging technology to precisely identify where an incision or repair is needed. It helps minimize damage to surrounding tissue and promotes faster patient recovery and reduced patient morbidity.

Optical Coherence Tomography (OCT)
Optical Coherence Tomography, or ‘OCT’, is a technique for obtaining sub-surface images of translucent or opaque materials at a resolution equivalent to a low-power microscope. It is effectively ‘optical ultrasound’, imaging reflections from within tissue to provide cross-sectional images. OCT is attracting interest among the medical community, because it provides tissue morphology imagery at much higher resolution (better than 10 µm) than other imaging modalities such as MRI or ultrasound.
